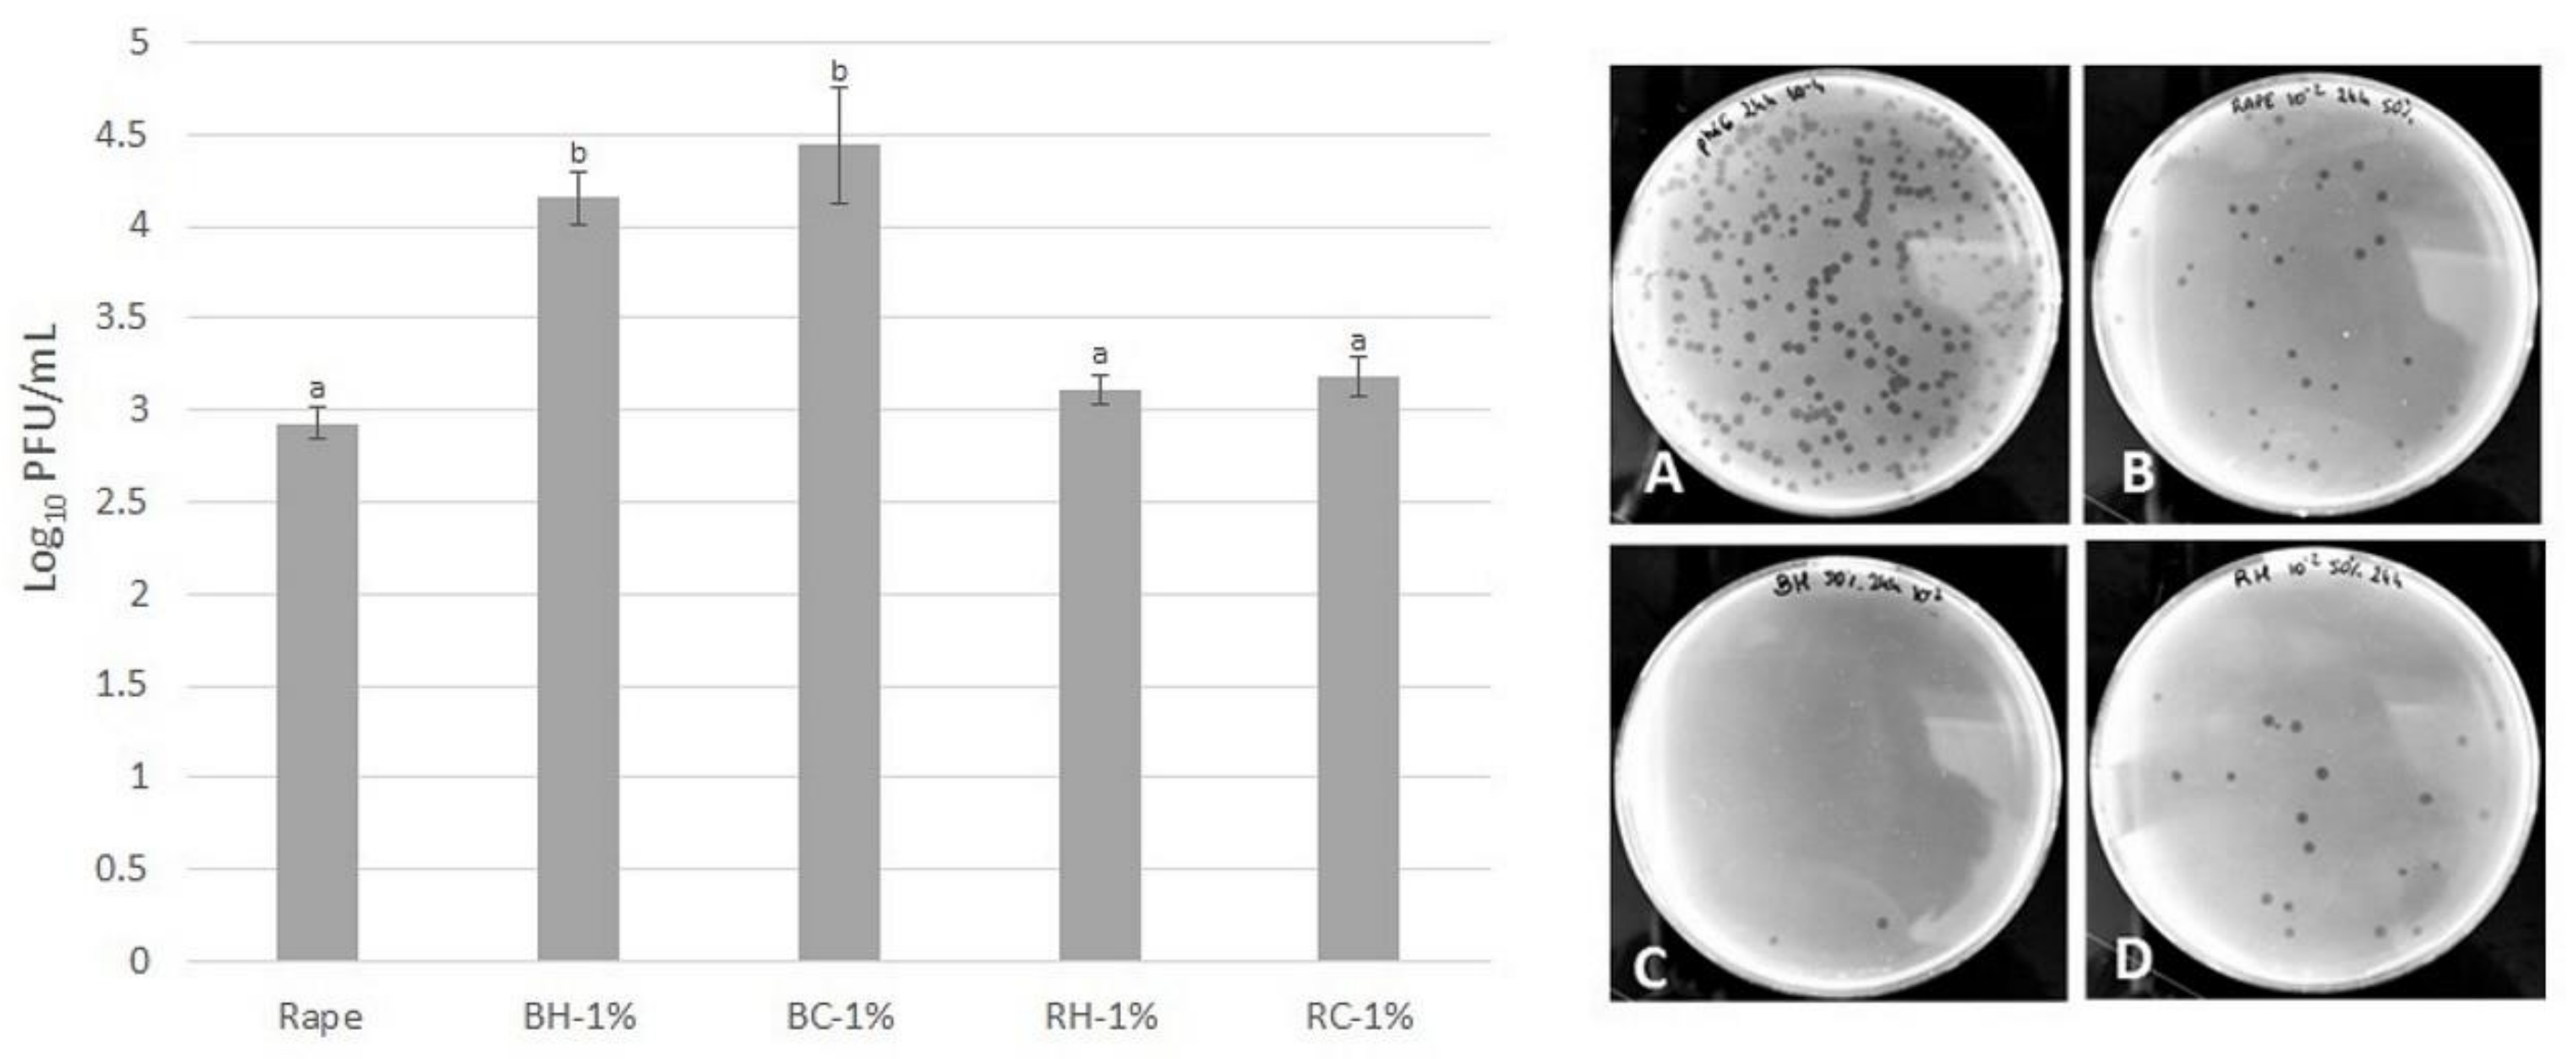
Molecules 27 04859 g006 Molecules 27 04859 g006

Antiviral and Antibacterial Effect of Honey Enriched with Rubus spp. as a Functional Food with Enhanced Antioxidant Properties
Abstract
1. Introduction
2. Results
2.1. The Comparison of Antioxidant Properties of Studied Rubus spp.
2.2. The Effect of Rubus spp. Addition on Antioxidant Properties of Honey
2.2.1. Antioxidant Activity and Polyphenols
2.2.2. HPTLC Polyphenolic Profile
2.3. HPLC Analysis
2.4. Antiviral Potential of Honey Enriched with Rubus spp.
2.5. Antibacterial Properties of Rubus spp.-Enriched Honeys
2.6. The Effect on Biofilm Formation
3. Materials and Methods
3.1. Reagents
3.2. Honey and Fruit Samples
3.3. Preparation of Rubus-Enriched Honeys
3.4. Sample Preparation for Analysis
3.5. Total Polyphenol Content (TPC)
3.6. Total Flavonoids Content (TFC)
3.7. Total Anthocyanins Content (TAC)
3.8. HPTLC Analysis—Polyphenolic Profile
3.9. HPLC-DAD Analysis
3.10. Antioxidant Properties
3.11. Antiviral Activity Determination
3.12. Antibacterial Properties
3.13. Assessment of S. aureus Biofilm Formation
3.14. Statistical Analysis
4. Conclusions
Supplementary Materials
Author Contributions
Funding
Institutional Review Board Statement
Informed Consent Statement
Data Availability Statement
Acknowledgments
Conflicts of Interest
Sample Availability
References
- Ali, A.; Rahut, D.B. Healthy Foods as Proxy for Functional Foods: Consumers’ Awareness, Perception, and Demand for Natural Functional Foods in Pakistan. Int. J. Food Sci. 2019, 2019, 6390650. [Google Scholar] [CrossRef] [PubMed]
- Natarajan, T.D.; Ramasamy, J.R.; Palanisamy, K. Nutraceutical potentials of synergic foods: A systematic review. J. Ethn. Food 2019, 6, 27. [Google Scholar] [CrossRef]
- Çakiroğlu, F.P.; Uçar, A. Consumer attitudes towards purchasing functional products. Prog. Nutr. 2018, 20, 257–262. [Google Scholar] [CrossRef]
- Pohorecka, K. Effect of standardized plant herb extracts on general condition of the honeybee (Apis mellifera L.). Bull. Vet. Inst. Pulawy 2004, 48, 415–419. [Google Scholar]
- Socha, R.; Juszczak, L.; Pietrzyk, S.; Fortuna, T. Antioxidant activity and phenolic composition of herbhoneys. Food Chem. 2009, 113, 568–574. [Google Scholar] [CrossRef]
- Guldas, M.; Gurbuz, O.; Cakmak, I.; Yildiz, E.; Sen, H. Effects of honey enrichment with Spirulina platensis on phenolics, bioaccessibility, antioxidant capacity and fatty acids. LWT 2022, 153, 112461. [Google Scholar] [CrossRef]
- Dżugan, M.; Sowa, P.; Kwaśniewska, M.; Wesołowska, M.; Czernicka, M. Physicochemical Parameters and Antioxidant Activity of Bee Honey Enriched With Herbs. Plant Foods Hum. Nutr. 2017, 72, 74–81. [Google Scholar] [CrossRef]
- Miłek, M.; Grabek-Lejko, D.; Stępeń, K.; Sidor, E.; Mołoń, M.; Dżugan, M. The enrichment of honey with Aronia melanocarpa fruits enhances its in vitro and in vivo antioxidant potential and intensifies its antibacterial and antiviral properties. Food Funct. 2021, 12, 8920–8931. [Google Scholar] [CrossRef]
- Tomczyk, M.; Miłek, M.; Sidor, E.; Kapusta, I.; Litwińczuk, W.; Puchalski, C.; Dżugan, M. The Effect of Adding the Leaves and Fruits of Morus alba to Rape Honey on Its Antioxidant Properties, Polyphenolic Profile, and Amylase Activity. Molecules 2019, 25, 84. [Google Scholar] [CrossRef]
- Santhi, V.P.; Sriramavaratharajan, V.; Murugan, R.; Masilamani, P.; Gurav, S.S.; Sarasu, V.P.; Parthiban, S.; Ayyanar, M. Edible fruit extracts and fruit juices as potential source of antiviral agents: A review. Food Meas. 2021, 15, 5181–5190. [Google Scholar] [CrossRef]
- Grabek-Lejko, D. Exploiting the antioxidant, anti-inflammatory, antimicrobial and anticancer potential of Rubus species. CAB Rev. Perspect. Agric. Vet. Sci. Nutr. Nat. Resour. 2015, 10, 201510014. [Google Scholar] [CrossRef]
- Burton-Freeman, B.M.; Sandhu, A.K.; Edirisinghe, I. Red Raspberries and Their Bioactive Polyphenols: Cardiometabolic and Neuronal Health Links. Adv. Nutr. 2016, 7, 44–65. [Google Scholar] [CrossRef]
- Nikolaeva-Glomb, L.; Mukova, L.; Nikolova, N.; Badjakov, I.; Dincheva, I.; Kondakova, V.; Doumanova, L.; Galabov, A.S. In Vitro Antiviral Activity of a Series of Wild Berry Fruit Extracts against Representatives of Picorna-, Orthomyxo- and Paramyxoviridae. Nat. Prod. Commun. 2014, 9, 51–54. [Google Scholar] [CrossRef]
- Kostecka-Gugała, A.; Ledwozyw-Smoleń, I.; Augustynowicz, J.; Wyzgolik, G.; Kruczek, M.; Kaszycki, P. Antioxidant properties of fruits of raspberry and blackberry grown in central Europe. Open Chem. 2015, 13, 1313–1325. [Google Scholar] [CrossRef]
- Oszmiański, J.; Wojdyło, A.; Nowicka, P.; Teleszko, M.; Cebulak, T.; Wolanin, M. Determination of phenolic compounds and antioxidant activity in leaves from wild Rubus L. species. Molecules 2015, 20, 4951–4966. [Google Scholar] [CrossRef]
- Costea, T.; Lupu, A.R.; Vlase, L.; Nencu, I.; Gîrd, C.E. Phenolic content and antioxidant activity of a raspberry leaf dry extract. Rom. Biotechnol. Lett. 2016, 21, 11346–11356. [Google Scholar]
- Dvaranauskaite, A.; Venskutonis, P.R.; Labokas, J. Comparison of quercetin derivatives in ethanolic extracts of red raspberry (Rubus idaeus L.) leaves. Acta Aliment. 2008, 37, 449–461. [Google Scholar] [CrossRef]
- Koczka, N.; Stefanovits-Bányai, É.; Prokaj, E. Element composition, total phenolics and antioxidant activity of wild and cultivated blackberry (Rubus fruticosus L.) fruits and leaves during the harvest time. Not. Bot. Horti Agrobot. Cluj-Napoca 2018, 46, 563–569. [Google Scholar] [CrossRef]
- Pavlović, A.V.; Papetti, A.; Zagorac, D.Č.D.; Gašić, U.M.; Mišić, D.M.; Tešić, Ž.L.; Natić, M.M. Phenolics composition of leaf extracts of raspberry and blackberry cultivars grown in Serbia. Ind. Crops Prod. 2016, 87, 304–314. [Google Scholar] [CrossRef]
- Ivanovic, J.; Tadic, V.; Dimitrijevic, S.; Stamenic, M.; Petrovic, S.; Zizovic, I. Antioxidant properties of the anthocyanin-containing ultrasonic extract from blackberry cultivar “Čačanska Bestrna”. Ind. Crops Prod. 2014, 53, 274–281. [Google Scholar] [CrossRef]
- Kryževičiute, N.; Kraujalis, P.; Venskutonis, P.R. Optimization of high pressure extraction processes for the separation of raspberry pomace into lipophilic and hydrophilic fractions. J. Supercrit. Fluids 2016, 108, 61–68. [Google Scholar] [CrossRef]
- Ziemlewska, A.; Zagórska-Dziok, M.; Nizioł-Łukaszewska, Z. Assessment of cytotoxicity and antioxidant properties of berry leaves as by-products with potential application in cosmetic and pharmaceutical products. Sci. Rep. 2021, 11, 3240. [Google Scholar] [CrossRef]
- Pantelidis, G.E.; Vasilakakis, M.; Manganaris, G.A.; Diamantidis, G. Antioxidant capacity, phenol, anthocyanin and ascorbic acid contents in raspberries, blackberries, red currants, gooseberries and Cornelian cherries. Food Chem. 2007, 102, 777–783. [Google Scholar] [CrossRef]
- Stamenković, Z.; Pavkov, I.; Radojčin, M.; Horecki, A.T.; Kešelj, K.; Kovačević, D.B.; Putnik, P. Convective drying of fresh and frozen raspberries and change of their physical and nutritive properties. Foods 2019, 8, 251. [Google Scholar] [CrossRef]
- Sablani, S.S.; Andrews, P.K.; Davies, N.M.; Walters, T.; Saez, H.; Bastarrachea, L. Effects of Air and Freeze Drying on Phytochemical Content of Conventional and Organic Berries. Dry. Technol. 2011, 29, 205–216. [Google Scholar] [CrossRef]
- Buřičová, L.; Andjelkovic, M.; Čermáková, A.; Réblová, Z.; Jurček, O.; Kolehmainen, E.; Verhé, R.; Kvasnička, F. Antioxidant capacity and antioxidants of strawberry, blackberry, and raspberry leaves. Czech J. Food Sci. 2011, 29, 181–189. [Google Scholar] [CrossRef]
- Ponder, A.; Hallmann, E. Phenolics and carotenoid contents in the leaves of different organic and conventional raspberry (Rubus idaeus L.) cultivars and their in vitro activity. Antioxidants 2019, 8, 458. [Google Scholar] [CrossRef]
- Lutz, M.; Hernández, J.; Henríquez, C. Phenolic content and antioxidant capacity in fresh and dry fruits and vegetables grown in Chile. CYTA-J. Food 2015, 13, 541–547. [Google Scholar] [CrossRef]
- Wilczyńska, A. Phenolic content and antioxidant activity of different types of polish honey—A short report. Polish J. Food Nutr. Sci. 2010, 60, 309–313. [Google Scholar]
- Kaczmarek, A.; Muzolf-Panek, M.; Tomaszewska-Gras, J.; Konieczny, P. Predicting the botanical origin of honeys with chemometric analysis according to their antioxidant and physicochemical properties. Polish J. Food Nutr. Sci. 2019, 69, 191–201. [Google Scholar] [CrossRef]
- Samborska, K.; Jedlińska, A.; Wiktor, A.; Derewiaka, D.; Wołosiak, R.; Matwijczuk, A.; Jamróz, W.; Skwarczyńska-Maj, K.; Kiełczewski, D.; Błażowski, Ł.; et al. The Effect of Low-Temperature Spray Drying with Dehumidified Air on Phenolic Compounds, Antioxidant Activity, and Aroma Compounds of Rapeseed Honey Powders. Food Bioprocess Technol. 2019, 12, 919–932. [Google Scholar] [CrossRef]
- Dżugan, M.; Tomczyk, M.; Sowa, P.; Grabek-Lejko, D. Antioxidant activity as biomarker of honey variety. Molecules 2018, 23, 2069. [Google Scholar] [CrossRef] [PubMed]
- Štajner, D.; Popović, B.M.; Čanadanović-Brunet, J.; Dilas, S.; Ćetković, G. Nutritive composition and free radical scavenger activity of honey enriched with of Rosa spp. LWT-Food Sci. Technol. 2014, 55, 408–413. [Google Scholar] [CrossRef]
- Zarei, M.; Fazlara, A.; Alijani, N. Evaluation of the changes in physicochemical and antioxidant properties of honey during storage. Funct. Foods Health Dis. 2019, 9, 593–605. [Google Scholar] [CrossRef]
- Šarić, G.; Marković, K.; Major, N.; Krpan, M.; Uršulin-Trstenjak, N.; Hruškar, M.; Vahčić, N. Changes of antioxidant activity and phenolic content in acacia and multifloral honey during storage. Food Technol. Biotechnol. 2012, 50, 434–441. [Google Scholar]
- Monggudal, M.B.; Radzi, M.N.F.M.; Ismail, M.M.; Ismail, W.I.W. Effect of Six Month Storage on Physicochemical Analysis and Antioxidant Activity of Several Types of Honey. IOP Conf. Ser. Mater. Sci. Eng. 2018, 440, 012047. [Google Scholar] [CrossRef]
- Staszowska-Karkut, M.; Materska, M. Phenolic composition, mineral content, and beneficial bioactivities of leaf extracts from black currant (Ribes nigrum L.), raspberry (Rubus idaeus), and aronia (Aronia melanocarpa). Nutrients 2020, 12, 463. [Google Scholar] [CrossRef]
- Remberg, S.F.; Soønsteby, A.; Aaby, K.; Heide, O.M. Influence of postflowering temperature on fruit size and chemical composition of glen ample raspberry (Rubus Idaeus L.). J. Agric. Food Chem. 2010, 58, 9120–9128. [Google Scholar] [CrossRef]
- Szymanowska, U.; Baraniak, B.; Bogucka-Kocka, A. Antioxidant, anti-inflammatory, and postulated cytotoxic activity of phenolic and anthocyanin-rich fractions from Polana Raspberry (Rubus idaeus L.) fruit and juice—In Vitro Study. Molecules 2018, 23, 1812. [Google Scholar] [CrossRef]
- Vara, A.L.; Pinela, J.; Dias, M.I.; Petrović, J.; Nogueira, A.; Soković, M.; Ferreira, I.C.F.R.; Barros, L. Compositional features of the “Kweli” red raspberry and its antioxidant and antimicrobial activities. Foods 2020, 9, 1522. [Google Scholar] [CrossRef]
- Fan-Chiang, H.J.; Wrolstad, R.E. Anthocyanin Pigment Composition of Blackberries. J. Food Sci. 2006, 70, C198–C202. [Google Scholar] [CrossRef]
- Dossett, M.; Lee, J.; Finn, C.E. Characterization of a novel anthocyanin profile in wild black raspberry mutants: An opportunity for studying the genetic control of pigment and color. J. Funct. Foods 2011, 3, 207–214. [Google Scholar] [CrossRef]
- Ştefǎnuţ, M.N.; Cǎta, A.; Pop, R.; Moşoarcǎ, C.; Zamfir, A.D. Anthocyanins HPLC-DAD and MS Characterization, Total Phenolics, and Antioxidant Activity of Some Berries Extracts. Anal. Lett. 2011, 44, 2843–2855. [Google Scholar] [CrossRef]
- Vega, E.N.; Molina, A.K.; Pereira, C.; Dias, M.I.; Heleno, S.A.; Rodrigues, P.; Fernandes, I.P.; Barreiro, M.F.; Stojković, D.; Soković, M.; et al. Anthocyanins from rubus fruticosus l. And morus nigra l. applied as food colorants: A natural alternative. Plants 2021, 10, 1181. [Google Scholar] [CrossRef]
- Vahidnia, F.; Stramer, S.L.; Kessler, D.A.; Shaz, B.; Leparc, G.; Krysztof, D.E.; Glynn, S.; Custer, B. Recent viral infection in US blood donors and health-related quality of life (HRQOL). Qual. Life Res. 2017, 26, 349–357. [Google Scholar] [CrossRef]
- Ben-Shabat, S.; Yarmolinsky, L.; Porat, D.; Dahan, A. Antiviral effect of phytochemicals from medicinal plants: Applications and drug delivery strategies. Drug Deliv. Transl. Res. 2020, 10, 354–367. [Google Scholar] [CrossRef]
- Woolhouse, M.; Scott, F.; Hudson, Z.; Howey, R.; Chase-Topping, M. Human viruses: Discovery and emergence. Philos. Trans. R. Soc. Lond. B Biol. Sci. 2012, 367, 2864–2871. [Google Scholar] [CrossRef]
- González, O.A.; Escamilla, C.; Danaher, R.J.; Dai, J.; Ebersole, J.L.; Mumper, R.J.; Miller, C.S. Antibacterial effects of blackberry extract target periodontopathogens. J. Periodontal Res. 2013, 48, 80–86. [Google Scholar] [CrossRef]
- De Santis, D.; Carbone, K.; Garzoli, S.; Laghezza Masci, V.; Turchetti, G. Bioactivity and Chemical Profile of Rubus idaeus L. Leaves Steam-Distillation Extract. Foods 2022, 11, 1455. [Google Scholar] [CrossRef]
- Grabek-Lejko, D.; Dżugan, M. Possible applications of honey in COVID-19 treatment—Potential mechanisms of action and overview of clinical trials. Możliwości wykorzystania miodu w terapii COVID-19—Potencjalne mechanizmy działania i przegląd badań klinicznych. Żywność Nauka Technol. Jakość/Food Sci. Technol. Qual. 2021, 28, 68–87. [Google Scholar] [CrossRef]
- RumLová, M.; RumL, T. In vitro methods for testing antiviral drugs. Biotechnol. Adv. 2018, 36, 557–576. [Google Scholar] [CrossRef]
- Prussin, A.J., II; Schwake, D.O.; Lin, K.; Gallagher, D.L.; Buttling, L.; Marr, L.C. Survival of the Enveloped Virus Phi6 in Dropletsas a Function of Relative Humidity, Absolute Humidity and Temperature. Appl. Environ. Microbiol. 2018, 84, e00551-18. [Google Scholar] [CrossRef]
- Serrano-Aroca, Á. Antiviral Characterization of Advanced Materials: Use of Bacteriophage Phi 6 as Surrogate of Enveloped Viruses Such as SARS-CoV-2. Int. J. Mol. Sci. 2022, 23, 5335. [Google Scholar] [CrossRef]
- Mizielinska, M.; Nawrotek, P.; Stachurska, X.; Ordon, M.; Bartkowiak, A. Packaging Covered with Antiviral and Antibacterial Coatings Based on ZnO Nanoparticles Supplemented with Geraniol and Carvacrol. Int. J. Mol. Sci. 2021, 22, 1717. [Google Scholar] [CrossRef]
- Ninfali, P.; Antonelli, A.; Magnani, M.; Scarpa, E.S. Antiviral Properties of Flavonoids and Delivery Strategies. Nutrients 2020, 12, 2534. [Google Scholar] [CrossRef]
- Chojnacka, K.; Skrzypczak, D.; Izydorczyk, G.; Mikula, K.; Szopa, D.; Witek-Krowiak, A. Antiviral Properties of Polyphenols from Plants. Foods 2021, 10, 2277. [Google Scholar] [CrossRef]
- Danaher, R.J.; Wang, C.; Dai, J.; Mumper, R.J.; Miller, C.S. Antiviral effects of blackberry extract against herpes simplex virus type 1. Oral Surg. Oral Med. Oral Pathol. Oral Radiol. Endod. 2011, 112, e31–e35. [Google Scholar] [CrossRef][Green Version]
- Bernier, C.; Goetz, C.; Jubinville, E.; Jean, J. The New Face of Berries: A Review of Their Antiviral Proprieties. Foods 2021, 11, 102. [Google Scholar] [CrossRef] [PubMed]
- Welia, A.M.; Al-Saadia, H.S.; Al-Fudhailia, R.S.; Hossaina, A.; Putitb, Z.B.; Jasim, M.K. Cytotoxic and antimicrobial potential of different leaves extracts of R. fruticosus used traditionally to treat diabetes. Toxicol. Rep. 2020, 7, 183–187. [Google Scholar] [CrossRef] [PubMed]
- Grabek-Lejko, D.; Wójtowicz, K. Comparison of antibacterial and antioxidant properties of fruits and leaves of blackberry (Rubus plicatus) and raspberry (Rubus idaeus). J. Microbiol. Biotechnol. Food Sci. 2014, 3, 514–518. [Google Scholar]
- Szweda, P. Antimicrobial Activity of Honey. In Honey Analysis; IntechOpen: London, UK, 2017. [Google Scholar] [CrossRef]
- Sakač, M.; Jovanov, P.; Marić, A.; Četojević-Simin, D.; Novaković, A.; Plavšić, D.; Škrobot, D.; Kovač, R. Antioxidative, Antibacterial and Antiproliferative Properties of Honey Types from the Western Balkans. Antioxidants 2022, 11, 1120. [Google Scholar] [CrossRef]
- Grecka, K.; Kuś, P.M.; Worobo, R.W.; Szweda, P. Study of the Anti Staphylococcal Potential of Honeys Produced in Northern Poland. Molecules 2018, 23, 260. [Google Scholar] [CrossRef]
- Nazzaro, F.; Fratianni, F.; d’Acierno, A.; Neve Ombra, M.; Caputo, L.; Coppola, R.; De Feo, V. Anti-Biofilm Properties Exhibited by Different Types of Monofloral Honey. Proceedings 2020, 66, 16. [Google Scholar] [CrossRef]
- Shirlaw, O.; Billah, Z.; Attar, B.; Hughes, L.; Qasaymeh, R.M.; Seidel, V.; Efthimiou, G. Antibiofilm Activity of Heather and Manuka Honeys and Antivirulence Potential of Some of Their Constituents on the DsbA1 Enzyme of Pseudomonas aeruginosa. Antibiotics 2020, 9, 911. [Google Scholar] [CrossRef]
- Biju, J.; Reddy, V.; Sulaiman, C.T. Total Phenolics and Flavonoids in Selected Justicia Species. J. Pharmacogn. Phytochem. 2013, 2, 51–52. [Google Scholar]
- Giusti, M.M.; Wrolstad, R.E. Characterization and Measurement of Anthocyanins by UV-Visible Spectroscopy. Curr. Protoc. Food Anal. Chem. 2001, F1.2.1–F1.2.13. [Google Scholar] [CrossRef]
- Vatter, P.; Hoenes, K.; Hessling, M. Photoinactivation of the Coronavirus Surrogate phi6 by Visible Light. Photochem. Photobiol. 2021, 97, 122–125. [Google Scholar] [CrossRef]
- Grabek-Lejko, D.; Słowik, J.; Kasprzyk, I. Activity of selected honey types against Staphylococcus aureus methicillin susceptible (MSSA) and methicillin resistant (MRSA) bacteria and its correlation with hydrogen peroxide, phenolic content and antioxidant capacity. Farmacia 2018, 66, 37–43. [Google Scholar]
- Coimbra, A.; Miguel, S.; Ribeiro, M.; Coutinho, P.; Silva, L.; Duarte, A.P.; Ferreira, S. Thymus zygis Essential Oil: Phytochemical Characterization, Bioactivity Evaluation and Synergistic Effect with Antibiotics against Staphylococcus aureus. Antibiotics 2022, 11, 146. [Google Scholar] [CrossRef]

| TPC [mg GAE/g d.m.] | TFC [mg QE/g d.m.] | TAC [mg Cy-3-glu/g d.m.] | FRAP [μmol TE/g d.m.] | DPPH [μmol TE/g d.m.] | ||
|---|---|---|---|---|---|---|
| BH | Leaf | 85.37 ± 3.31 a | 11.59 ± 0.36 a | - | 496.13 ± 11.51 a | 295.97 ± 17.02 a |
| Fruit | 28.68 ± 0.15 b | 0.42 ± 0.03 b | 4.79 ± 0.01 a | 191.69 ± 3.14 b | 94.81 ± 0.34 b | |
| BC | Leaf | 45.87 ± 0.16 c | 4.06 ± 0.08 c | - | 283.47 ± 3.84 c | 194.19 ± 26.88 c |
| Fruit | 27.73 ± 0.24 b | 0.44 ± 0.02 b | 3.79 ± 0.01 b | 180.47 ± 1.92 b | 86.87 ± 1.36 b,d | |
| RH | Leaf | 52.96 ± 0.24 d | 13.82 ± 0.12 d | - | 276.19 ±1.57 b,c | 178.71 ± 0.63 c |
| Fruit | 20.65 ± 0.00 e | 0.25 ± 0.01 b | 2.53 ± 0.00 c | 125.70 ± 1.22 d | 65.33 ± 1.53 d | |
| RC | Leaf | 27.57 ± 3.95 b | 3.89 ± 0.24 c | - | 172.82 ± 1.57 b | 109.61 ± 0.63 b |
| Fruit | 18.97 ± 0.16 e | 0.24 ± 0.02 b | 2.90 ± 0.00 d | 123.36 ± 3.49 d | 61.48 ± 1.87 d | |
| TPC [mg GAE/kg] | TFC [mg QE/kg] | FRAP [mmol TE/kg] | DPPH [mmol TE/kg] | ||
|---|---|---|---|---|---|
| control | 355.65 ± 2.10 | 91.6 ± 4.32 | 0.59 ± 0.01 | 0.53 ± 0.06 | |
| BH | +Leaf 0.5% | 875.00 ± 46.30 | 163.36 ± 15.11 | 3.09 ± 0.25 | 2.61 ± 0.45 |
| +Leaf 1% | 1550.6 ± 40.87 | 232.06 ± 0.00 | 5.85 ± 0.22 | 6.07 ± 0.08 | |
| +Fruit 1% | 650.30 ± 2.10 | 146.56 ± 8.64 | 1.88 ± 0.02 | 2.16 ± 0.35 | |
| +Fruit 4% | 1282.73 ± 139.90 | 245.08 ± 9.43 | 4.66 ± 0.14 | 3.94 ± 0.11 | |
| BC | +Leaf 0.5% | 721.73 ± 23.15 | 77.86 ± 2.16 | 2.01 ± 0.09 | 1.77 ± 0.07 |
| +Leaf 1% | 1400.29 ± 6.31 | 213.74 ± 4.32 | 8.05 ± 0.32 | 4.33 ± 0.11 | |
| +Fruit 1% | 940.47 ± 24.40 | 170.99 ± 4.32 | 2.64 ± 0.03 | 2.21 ± 0.55 | |
| +Fruit 4% | 1514.88 ± 54.72 | 319.08 ± 2.16 | 5.39 ± 0.13 | 4.22 ± 0.43 | |
| RH | +Leaf 0.5% | 717.26 ± 4.21 | 213.74 ± 8.64 | 2.06 ± 0.09 | 1.76 ± 0.03 |
| +Leaf 1% | 1449.41 ± 29.46 | 425.95 ± 6.48 | 5.17 ± 0.08 | 5.32 ± 0.11 | |
| +Fruit 1% | 552.08 ± 2.10 | 68.70 ± 2.16 | 1.55 ± 0.07 | 1.51 ± 0.37 | |
| +Fruit 4% | 1050.59 ± 33.67 | 204.58 ± 12.95 | 3.82 ± 0.05 | 2.62 ± 0.02 | |
| RC | +Leaf 0.5% | 863.10 ± 29.46 | 175.57 ± 6.48 | 2.43 ± 0.17 | 2.21 ± 0.11 |
| +Leaf 1% | 1385.42 ± 31.57 | 213.74 ± 8.64 | 4.71 ± 0.29 | 3.97 ± 0.30 | |
| +Fruit 1% | 601.19 ± 12.63 | 79.39 ± 3.23 | 1.55 ± 0.03 | 1.52 ± 0.52 | |
| +Fruit 4% | 1197.92 ± 23.15 | 285.50 ± 6.48 | 4.25 ± 0.05 | 3.21 ± 0.13 | |
| TPC | TFC | FRAP | DPPH | |
|---|---|---|---|---|
| TPC | 1 | |||
| TFC | 0.807 | 1 | ||
| FRAP | 0.926 | 0.682 | 1 | |
| DPPH | 0.951 | 0.774 | 0.887 | 1 |
Publisher’s Note: MDPI stays neutral with regard to jurisdictional claims in published maps and institutional affiliations. |
© 2022 by the authors. Licensee MDPI, Basel, Switzerland. This article is an open access article distributed under the terms and conditions of the Creative Commons Attribution (CC BY) license (https://creativecommons.org/licenses/by/4.0/).
Share and Cite
Grabek-Lejko, D.; Miłek, M.; Sidor, E.; Puchalski, C.; Dżugan, M. Antiviral and Antibacterial Effect of Honey Enriched with Rubus spp. as a Functional Food with Enhanced Antioxidant Properties. Molecules 2022, 27, 4859. https://doi.org/10.3390/molecules27154859
Grabek-Lejko D, Miłek M, Sidor E, Puchalski C, Dżugan M. Antiviral and Antibacterial Effect of Honey Enriched with Rubus spp. as a Functional Food with Enhanced Antioxidant Properties. Molecules. 2022; 27(15):4859. https://doi.org/10.3390/molecules27154859
Chicago/Turabian StyleGrabek-Lejko, Dorota, Michał Miłek, Ewelina Sidor, Czesław Puchalski, and Małgorzata Dżugan. 2022. "Antiviral and Antibacterial Effect of Honey Enriched with Rubus spp. as a Functional Food with Enhanced Antioxidant Properties" Molecules 27, no. 15: 4859. https://doi.org/10.3390/molecules27154859
APA StyleGrabek-Lejko, D., Miłek, M., Sidor, E., Puchalski, C., & Dżugan, M. (2022). Antiviral and Antibacterial Effect of Honey Enriched with Rubus spp. as a Functional Food with Enhanced Antioxidant Properties. Molecules, 27(15), 4859. https://doi.org/10.3390/molecules27154859

